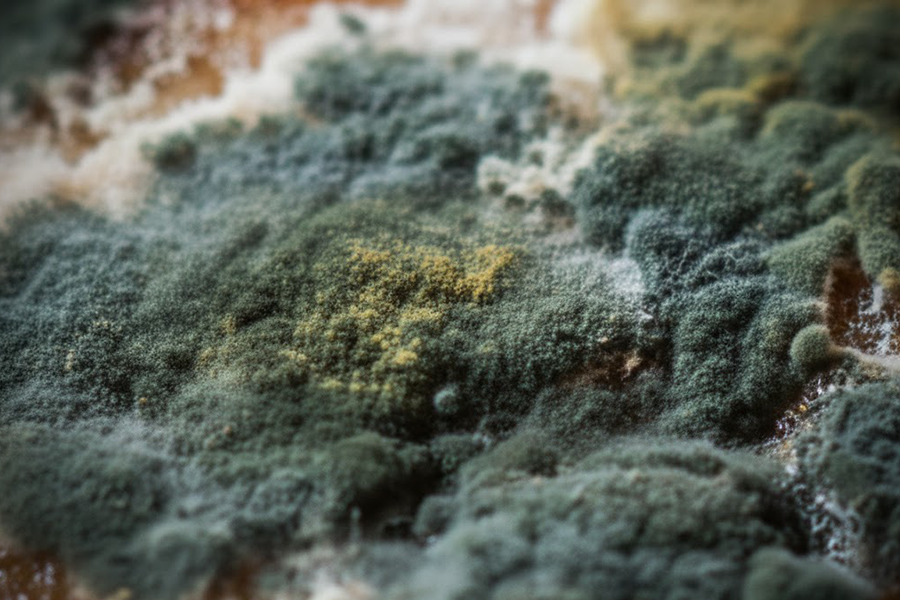
黃麴毒素

作者\基因醫師張家銘
過年到現在,家裡的年糕還好嗎?
過年到現在,不少年糕早已開始發霉,看到這些白色、綠色、黃色、甚至黑色的霉斑時,大家應該會想問:「這些黴菌到底是什麼?它們對健康有沒有影響?」我們是否能把年糕的發霉視為「天然發酵」,像起司那樣,還是應該堅決丟棄?
為了釐清這個問題,我特別查閱了相關研究,發現年糕霉菌的研究確實很少,但有篇食品科技的文獻透過 PCR 檢測霉菌 DNA 序列,準確鑑定了年糕上生長的主要黴菌種類。
結果顯示,年糕上的霉菌種類多樣,但最具風險的,是與黃麴毒素相關的黃麴霉(Aspergillus flavus)。

年糕發霉別吃!小心隱藏的致癌危機
年糕發霉後,常見的黴菌有哪些?
- 黃麴霉(Aspergillus flavus)
會產生黃麴毒素,這是一種強烈致癌物,與肝癌高度相關。
- 雜色麴霉(Aspergillus terreus 或 Aspergillus versicolor)
影響食品品質,可能帶來毒素污染。
- 草酸青霉(Penicillium oxalicum)
主要影響食物風味,毒性相對較低,但仍不建議食用。
- 短密青霉(Penicillium brevicompactum)
可能產生赭麴毒素(Ochratoxin),這是一種影響腎臟健康的黴菌毒素。
- 黃色籃狀菌(Eurotium spp.)
多見於低水分食品,可能產生次級代謝物,影響食物品質與安全性。
其中,最具危險性的就是黃麴霉,因為它會產生黃麴毒素,這是一種耐熱且極難去除的致癌物。
- 黃麴毒素:隱藏在發霉年糕中的致癌物
黃麴毒素是由黃麴霉(Aspergillus flavus)產生,被世界衛生組織(WHO)列為一級致癌物。許多研究顯示,東亞與東南亞地區的肝癌發生率較高,與食品中黃麴毒素污染有密切關聯。
長期攝取黃麴毒素,可能導致:肝硬化、慢性肝炎或是肝癌
更令人擔憂的是,黃麴毒素極其耐熱,常見的烹調方式無法破壞它:
- 蒸煮 100°C:無法完全破壞黃麴毒素
- 油炸 180 至 200°C:毒素仍然殘留
- 烘烤 250°C:部分降解,但仍無法完全消除
這代表,無論蒸、炸、烤,毒素依然存在。只要吃下去,就有可能慢慢累積在體內,對健康造成長期傷害。

年糕上的黴菌顏色代表什麼?
黴菌的顏色與其種類有關,根據食品微生物學分析,年糕上常見的黴菌顏色與其種類如下:
- 綠色黴菌
可能的黴菌種類:青霉屬(Penicillium spp.), 特徵:青綠色或暗綠色的絨毛狀菌落,通常出現在存放較久或潮濕的年糕表面。
- 黃色黴菌
可能的黴菌種類:黃麴霉(Aspergillus flavus), 特徵:菌落呈黃色至黃褐色,是最危險的黴菌之一,可能產生黃麴毒素,與肝癌有關。
- 白色黴菌
可能的黴菌種類:酵母菌(Yeast spp.)或某些早期生長的黴菌, 特徵:白色棉絮狀或點狀生長,初期可能不易察覺,但隨時間可能變成其他顏色。
- 灰色黴菌
可能的黴菌種類:某些麴霉屬(Aspergillus spp.)或黑麴霉(Aspergillus niger),特徵:菌落呈灰色至深灰色,可能伴隨粉狀孢子或絨毛狀結構。
- 黑色黴菌
可能的黴菌種類:黑麴霉(Aspergillus niger),特徵:黑色或深棕色菌落,常見於存放過久或受潮嚴重的年糕上,可能影響呼吸系統健康。
發霉食物與發酵食品的差異
許多食品,如藍紋起司、納豆、紅麴等,都是透過特定黴菌發酵,經過可控培養後成為安全食品。然而,不受控環境下的發霉食品,則可能含有有毒黴菌,如黃麴毒素,應立即丟棄。
關鍵在於辨別「可控發酵」與「不受控腐敗」。一旦食物出現異常氣味、顏色、黴菌斑點,應立即停止食用,以確保健康安全。發霉的年糕不能吃,唯一安全的做法就是直接丟棄!
【基因醫師張家銘】授權轉載 原文刊自【過年到現在,家裡的年糕還好嗎?】
年糕發霉常見問題FAQs
年糕發霉後可以切掉發霉部分繼續吃嗎?
不行!黴菌的菌絲可能已經深入年糕內部,即使表面看起來乾淨,仍有毒素殘留。
黃麴毒素對人體的影響是什麼?
長期攝取可能導致肝硬化、慢性肝炎,甚至提高肝癌風險。
年糕該如何保存才能防止發霉?
購買後保存在陰涼通風處,如沒有要馬上吃建議切片後放保鮮盒冷藏或冷凍保存,並儘快食用完畢。
延伸閱讀
大S流感併發肺炎猝逝!春節後流感疫情升溫,4大高風險族群須注意












